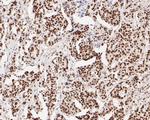
Tat-SF1 Antibody in Immunohistochemistry (Paraffin) (IHC (P))

Search
Invitrogen
Tat-SF1 Recombinant Rabbit Monoclonal Antibody (JE54-89)
{{$productOrderCtrl.translations['antibody.pdp.commerceCard.promotion.promotions']}}
{{$productOrderCtrl.translations['antibody.pdp.commerceCard.promotion.viewpromo']}}
{{$productOrderCtrl.translations['antibody.pdp.commerceCard.promotion.promocode']}}: {{promo.promoCode}} {{promo.promoTitle}} {{promo.promoDescription}}. {{$productOrderCtrl.translations['antibody.pdp.commerceCard.promotion.learnmore']}}
图: 1 / 9
Tat-SF1 Antibody (MA5-36200) in ICC/IF

产品信息
MA5-36200
种属反应
宿主/亚型
Expression System
分类
类型
克隆号
抗原
偶联物
形式
浓度
规格
纯化类型
保存液
内含物
保存条件
运输条件
RRID
靶标信息
The protein encoded by this gene functions as a cofactor for the stimulation of transcriptional elongation by HIV-1 Tat, which binds to the HIV-1 promoter through Tat-TAR interaction. This protein may also serve as a dual-function factor to couple transcription and splicing and to facilitate their reciprocal activation. Alternatively spliced transcript variants have been found for this gene.
仅用于科研。不用于诊断过程。未经明确授权不得转售。
篇参考文献 (0)
生物信息学
蛋白别名: 17S U2 SnRNP complex component HTATSF1; cofactor required for Tat activation of HIV-1 transcription; HIV TAT specific factor 1; HIV Tat-specific factor 1; HIV Tat-specific factor 1 homolog; RP1-196E23.2; similar to EWS and FUS/TLS77; Tat-SF1; unnamed protein product
基因别名: 1600023H17Rik; 2600017A12Rik; 2700077B20Rik; dJ196E23.2; HTATSF1; TAT-SF1; TATSF1
UniProt ID: (Human) O43719, (Mouse) Q8BGC0
Entrez Gene ID: (Human) 27336, (Mouse) 72459




